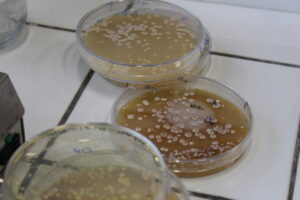

Temps de lecture : 3 minutes
Du 22 au 26 septembre 2025, la Faculté des Sciences et Technologies a organisé la Semaine de la Recherche, un événement phare destiné à mettre en avant le lien étroit entre formation et recherche sur le site lorrain. Des conférences, des visites de laboratoires et des rencontres avec chercheurs et doctorants ont permis aux étudiants de s’immerger dans le quotidien de la recherche scientifique.
Parmi les temps forts, les visites de laboratoires ont offert une immersion concrète dans le travail des chercheurs. Au laboratoire Dynamique des Génomes et Adaptation Microbienne (DynAMic), les étudiants ont découvert les méthodes de culture et de conservation des bactéries, observé les paillasses et les espaces de travail, et exploré les cultures utilisées pour étudier la production d’antibiotiques. Yvonne Roussel, enseignante-chercheuse, a guidé le groupe avec pédagogie, répondant à de nombreuses questions. Certaines salles dégageaient des odeurs caractéristiques, telles que celles du yaourt ou du sous-bois, associées aux Streptomyces ou Streptococcus thermophilus, offrant une expérience sensorielle et scientifique inoubliable. Pour Esther, étudiante en 3ème année de Licence, cette immersion a renforcé son intérêt pour les microorganismes : « Les bactéries, c’est supérieur ! »

La semaine a également été marquée par des rencontres avec des personnalités inspirantes. Sarah Xing, ancienne étudiante de la FST et présidente de CRYOSCAN, a partagé son parcours jusqu’à sa thèse à l’Institut Jean Lamour (IJL), puis son implication dans l’instrumentation scientifique de pointe. « Ce qui me motive chaque matin, c’est de voir que les instruments de recherche peuvent avoir un impact concret sur le monde industriel ». Elle souligne l’importance de découvrir les différentes formes que peuvent prendre la recherche expérimentale, théorique ou appliquée, ainsi que le rôle essentiel des doctorants, des ingénieurs et des techniciens. Son témoignage montre comment la curiosité et la passion peuvent transformer un projet universitaire en une carrière à fort impact.
La Semaine de la Recherche a également mis en avant les dispositifs et clubs ORION (Osez la Recherche durant la formatION), qui font le lien entre les études et la recherche. Les clubs – Mat&Met, Chem4Life, What Health, Bionysos, SYSTEMIC, SAN/socieTE, In Vivox, et METRO-LOGIC – ont présenté leurs activités et leurs projets, donnant aux étudiants un aperçu concret de la diversité des thématiques et des méthodes de recherche. Les discussions avec les doctorants et les enseignants-chercheurs ont permis de mieux comprendre les débouchés et les perspectives offertes par la recherche, tant dans le milieu universitaire que dans l’industrie.
Au-delà des aspects scientifiques, cet événement a mis en évidence la richesse humaine de la profession. Les visites et les conférences ont permis aux étudiants de discuter directement avec les chercheurs, de comprendre le quotidien d’un laboratoire et de réfléchir à leur avenir, que ce soit pour des stages, des spécialisations ou des poursuites d’études.
L’édition 2025 a tenu toutes ses promesses : donner aux participants un aperçu des coulisses de la recherche, inspirer des vocations, renforcer le lien entre formation et recherche, et montrer que la science est avant tout une aventure collective et passionnante. Avec des découvertes concrètes, des échanges inspirants et des perspectives d’avenir, la Semaine de la Recherche a offert un aperçu dynamique de la vitalité scientifique du site lorrain.




![Vers l'article [8 mars] Lucie Bourdon, boursière d’excellence ORION : entre biologie marine et écotoxicologie](https://factuel.univ-lorraine.fr/wp-content/uploads/2026/03/Lucie--600x600.jpg)
![Vers l'article [Retour sur] Apéro scientifique du club ORION Sexteens : La place des femmes dans La Servante Écarlate](https://factuel.univ-lorraine.fr/wp-content/uploads/2026/02/sexteens5-600x450.jpg)







![Vers l'article [Sexpop #2] Apéro scientifique : La place des femmes dans la série La Servante Écarlate](https://factuel.univ-lorraine.fr/wp-content/uploads/2026/02/Affiche-apero-servante-ecarlate_factuel-212x300.jpg)

